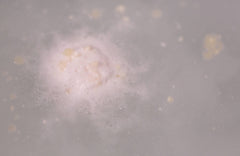
Butterball

Before you leave...
Take 20% off your first order
20% off
Enter the code below at checkout to get 20% off your first order
Free Shipping On All Orders.

Couldn't load pickup availability
Free standard shipping on orders
Free Worldwide Shipping & Duties Covered
We are pleased to offer Free Worldwide Shipping on all orders, delivering to all countries and regions supported by our logistics network. There are no restrictions on order quantity, parcel size, or shipment weight — every order ships at no cost to you. In addition, all customs duties, import taxes, and government-imposed fees associated with your shipment will be fully covered by us, ensuring you will not incur any extra charges upon delivery.
Please note that delivery times may vary due to local customs procedures and carrier conditions, but your shipping and customs costs will remain completely free under this policy.
We provide a secure and reliable Free Returns service for all customers. Items that remain unused and unopened may be returned within 60 days for a full refund.
All return shipping expenses, including customs-related fees, are fully covered by us.
Refund processing will be completed within 4 weeks from the date the return shipment is sent, regardless of whether the package has arrived at our facility. In general, refunds are finalized significantly earlier, ensuring a smooth and dependable experience.
Allure Best of Beauty 2023
It may look unassuming, but don't let that fool you: this fizzer is nothing less than a little slice of bathing heaven. Pop it into your tub and lie back among a dreamy sweet scent and a blanket of creamy, buttery froth. Hot baths can leave your skin feeling dried out, but Butterball's generous flecks of fair trade organic cocoa butter keep every inch of your skin soft and hydrated. Made in Canada.
Benefits:
- Cocoa butter softens skin
- Ylang ylang oil soothes moods
- Our fair trade organic cocoa butter is grown by farmers in eastern Congo (DRC). We pay a premium that allows them to invest in their local communities.
How to use:
Fill your bathtub with warm water, drop in the bath bomb and lie back to enjoy its lovely color and gorgeous fragrance.
How to store:
Keep bath bombs fresh and dry in one of our bath bomb or product holders, a big glass jar or anything else that keeps them away from water.
Thanks for subscribing!
This email has been registered!
Take 20% off your first order
Enter the code below at checkout to get 20% off your first order